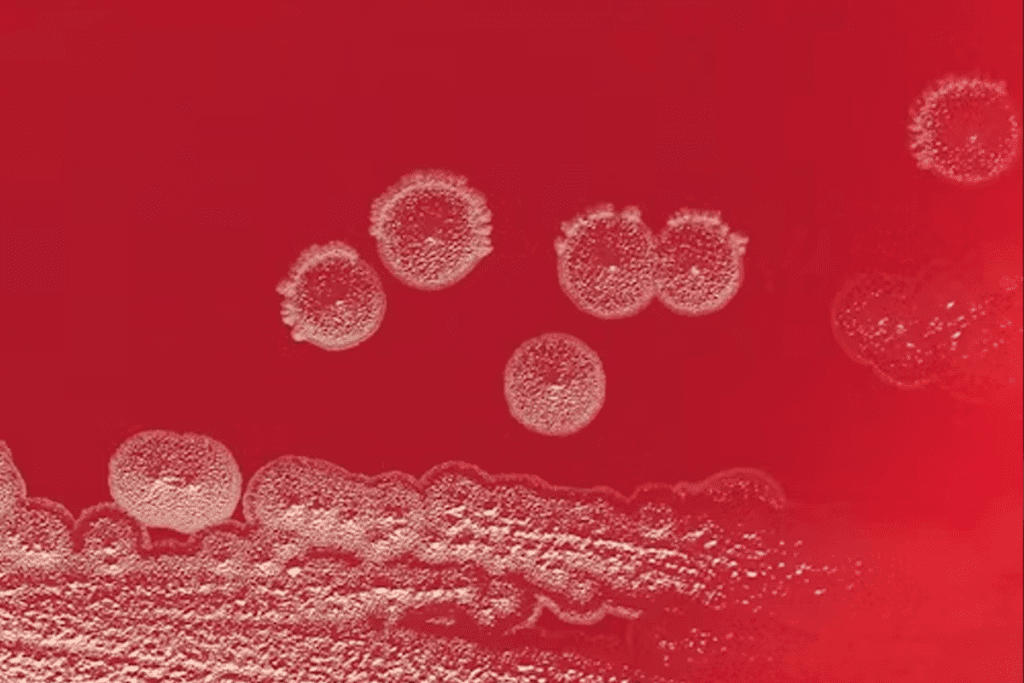
Cell Regeneration: Powerful Fasting Secrets for Longevity 3 Cell Regeneration: Powerful Fasting Secrets for Longevity

Last Updated on December 1, 2025 by Bilal Hasdemir

cell regeneration
Fasting has been shown to significantly enhance overall health. Studies show it can slow down age-related diseases and even increase lifespan. A study by Emmanuelle Passegué found that a 24-hour fasting period followed by refeeding can rejuvenate blood stem cells. This shows fasting’s power in promoting longevity.
This finding has made people curious about fasting’s role in cell regeneration. Knowing the right fasting time is key for those wanting to use it for health benefits.
Key Takeaways
- Fasting can delay age-related diseases and lengthen lifespan.
- A 24-hour fasting period can rejuvenate blood stem cells.
- Fasting promotes longevity and overall health.
- Optimal fasting duration is key for cell regeneration.
- Fasting has many health benefits beyond cell regeneration.
The Science Behind Cellular Renewal During Fasting

Fasting starts a chain of events that helps keep our bodies in balance. When we fast, our bodies start using fat for energy instead of glucose. This change leads to many metabolic shifts.
How Fasting Triggers Cellular Repair Mechanisms
Fasting starts autophagy, a natural process where cells clean out damaged parts. This recycling is key for keeping cells healthy and renewing them. Autophagy kicks in when the body is stressed, like during fasting, to remove damaged parts and keep cells balanced.
The steps of autophagy are:
- Autophagosomes form, which are structures that grab damaged parts of cells.
- These autophagosomes then merge with lysosomes, where the damaged parts are broken down and reused.
The Metabolic Pathways Involved in Regeneration
When we fast, our body starts using certain pathways to help cells heal. One important pathway is the activation of stem cells. These cells are vital for fixing and growing new tissues. Fasting boosts stem cell production, helping our body fix damaged areas.
Fasting also leads to the creation of proteins and hormones that help fix cells. For example, fasting increases brain-derived neurotrophic factor (BDNF). This is important for keeping brain cells healthy and growing.
The main metabolic pathways at work are:
- Reducing insulin-like growth factor 1 (IGF-1), which is linked to aging and cancer.
- Starting cellular cleaning processes, like autophagy.
- Boosting stem cell production for tissue repair.
Understanding Autophagy: The Cell Regeneration Process
autophagy process
Autophagy is a complex process that helps cells regenerate. It is greatly enhanced by fasting. The term “autophagy” comes from the Greek words “auto” meaning self and “phagy” meaning eating. It’s a natural way for cells to recycle and remove damaged parts.
What is autophagy and how it works
Autophagy is a key process that keeps cells healthy. It helps cells get rid of damaged parts and recycle them. This process uses double-membraned structures called autophagosomes to break down damaged organelles and proteins.
When cells are fasting, autophagy kicks in. It helps cells survive by recycling their own parts. Autophagy is key for removing damaged parts and keeping cells healthy.
The timeline of autophagy activation during fasting
The time it takes for autophagy to start can vary. Studies show it can start within 24 hours of fasting. But, it really kicks in between 48 to 72 hours. Prolonged fasting leads to more autophagy, helping cells regenerate more.
Knowing when autophagy starts is important. By fasting the right way, people can boost their cell renewal and health.
Fasting Timeframes for Cell Regeneration
fasting timeframes for cell regeneration
The length of fasting is key to its effects on cells. Different fasting times lead to different responses in the body. These responses help cells renew themselves.
12-16 hours: Initial Metabolic Shifts
Fasting for 12 to 16 hours starts the body’s change to using fat for energy. This is the first step in regenerating cells.
24-48 hours: Enhanced Autophagy Begins
Fasting for 24 to 48 hours boosts autophagy. Autophagy is when cells clean out old or damaged parts. This can make cells work better and improve health.
72 hours: Maximum Stem Cell Production
A 72-hour fast, or a three-day fast, is best for making new stem cells. These cells can turn into different types, helping repair and grow tissues.
5+ days: Extended Regenerative Effects
Fasting for more than 5 days brings more benefits. Prolonged fasting can improve the immune system and clean cells better.
In summary, how long you fast affects its cell-regenerating power. Knowing the benefits of different fasting times helps tailor fasting plans for better results.
Intermittent Fasting Methods for Cellular Health
intermittent fasting methods
Intermittent fasting offers many ways to boost cell renewal. It gives people options to better their health.
16:8 Method and Its Effects on Cell Renewal
The 16:8 method means fasting for 16 hours and eating in an 8-hour window. It helps improve cell health by boosting autophagy. Autophagy is when cells clean out damaged parts.
Benefits of the 16:8 Method:
- Improved insulin sensitivity
- Enhanced autophagy
- Increased human growth hormone production
OMAD (One Meal a Day) and Autophagy Benefits
OMAD means eating just one meal a day, in a one-hour window. It boosts autophagy and helps cells renew.
Key advantages of OMAD include:
- Increased autophagy
- Improved mental clarity
- Simplified eating schedule
5:2 Approach for Weekly Regeneration
The 5:2 diet lets you eat normally for five days. Then, you eat only 500-600 calories for two days. It helps cells regenerate and improves health.
| Fasting Method | Duration | Benefits |
| 16:8 | 16 hours fasting, 8 hours eating | Improved insulin sensitivity, enhanced autophagy |
| OMAD | 23 hours fasting, 1 hour eating | Increased autophagy, improved mental clarity |
| 5:2 | 2 days calorie restriction | Promotes cellular regeneration, improves overall health |
Adding these fasting methods to your life can boost your cell health and well-being.
The 72-Hour Fast: The Gold Standard for Cell Regeneration
The 72-hour fast is backed by science as the best time for cell regeneration. This time allows for big changes in how the body works. It helps cells renew themselves.
Why three days is considered optimal
Fasting for 72 hours starts a chain of cell processes important for regeneration. The body uses up glucose and starts breaking down fat for energy. This supports cell repair.
Key benefits of a 72-hour fast include:
- Enhanced autophagy, where cells recycle damaged or dysfunctional components
- Increased production of stem cells, which are vital for tissue repair and regeneration
- A complete reset of the immune system, helping to eliminate damaged or aged immune cells
Complete immune system reset at 72 hours
A 72-hour fast has been shown to reset the immune system completely. It gets rid of old immune cells and makes new ones. This can make the immune system work better.
Studies have demonstrated that long fasting can reduce inflammation and improve immune function.
| Fasting Duration | Effects on Immune System | Cell Regeneration Benefits |
| 12-16 hours | Initial shift to fat metabolism | Early stages of autophagy |
| 24-48 hours | Enhanced autophagy begins | Increased cellular cleaning and renewal |
| 72 hours | Complete immune system reset | Maximum stem cell production |
Scientific studies supporting the three-day threshold
Many studies have looked into how long fasting affects cell regeneration and the immune system. Research in Cell Stem Cell and Aging Cell journals shows the benefits of a 72-hour fast.
These studies found that fasting for three days boosts stem cell production and resets the immune system. This shows the promise of long fasting for health.
Prolonged Fasting: Benefits and Considerations Beyond 3 Days
Prolonged fasting goes beyond three days, showing a deeper approach to health. Shorter fasts start good processes like autophagy and stem cell activation. Longer fasts might make these effects stronger.
Extended Autophagy Effects
Autophagy, the body’s way of recycling old or damaged cells, gets better with longer fasting. Without new food, the body uses what it has, leading to more cell renewal.
- Increased breakdown and recycling of damaged cellular components
- Enhanced removal of pathogens and toxic substances
- Potential for improved cellular function and resilience
Stem Cell Activation in Longer Fasts
Longer fasting boosts stem cell production, key for fixing and growing tissues. This can lead to:
- Regeneration of damaged tissues
- Potential improvement in organ function
- Enhanced overall health and resilience
Safety Considerations and Diminishing Returns
Longer fasting has many benefits but also risks and limits. It can cause:
- Nutritional deficiencies if not properly managed
- Potential negative impacts on certain populations (e.g., the elderly, those with chronic conditions)
- Diminishing returns beyond a certain fasting duration
It’s key to be careful with long fasting, seeking a healthcare expert’s advice. This way, you can enjoy the benefits while avoiding the risks.
How to Safely Practice Fasting for Optimal Cell Regeneration
When you start fasting, it’s important to do it safely. This ensures you get the most benefits for your body. Here are some tips to help you fast safely and effectively.
First, make sure you’re well-hydrated. Drink plenty of water during your fasting periods. This helps your body function well and keeps you feeling good.
Listen to your body and stop if you feel too weak or dizzy. It’s okay to take breaks if you need to. Your health is more important than sticking to a strict fasting schedule.
It’s also key to talk to a healthcare professional before starting any fasting plan. They can give you personalized advice based on your health needs. This ensures you’re fasting safely and effectively.
By following these tips, you can safely practice fasting. This helps your body regenerate cells and feel better overall.
Who Should Not Fast for Cell Regeneration
Fasting can help with cell regeneration, but it’s not for everyone. It’s important to know who should be careful or avoid it.
Medical Contraindications
Some health issues make fasting risky. Here are a few examples:
- Diabetes: Fasting can cause blood sugar levels to drop too low or rise too high.
- Pregnancy and Breastfeeding: These times need more nutrients, and fasting can deprive the baby or child of them.
- Eating Disorders: Fasting can make eating disorders like anorexia worse.
- Certain Cardiovascular Conditions: Fasting can lead to dehydration and imbalances in electrolytes, which can harm the heart.
| Medical Condition | Risks Associated with Fasting |
| Diabetes | Blood sugar fluctuations, risk of low or high blood sugar |
| Pregnancy/Breastfeeding | Nutritional deficiencies, dehydration |
| Eating Disorders | Worsening of the condition, risk of malnutrition |
Risk Factors to Consider
Even without a specific health issue, some factors are important:
- Age: Older people might face more risks from dehydration and nutrient deficiencies.
- Chronic Medications: Some medicines need food to work right or to avoid side effects.
- History of Malnutrition: Fasting can make nutritional deficiencies worse.
When to Consult a Healthcare Provider
Before starting a fasting plan, talk to a doctor if you:
- Have any health conditions
- Take prescription drugs
- Worry about your health or nutrition
A doctor can check if fasting is safe for you. They can also offer advice on how to stay safe while fasting.
Conclusion: Personalizing Your Fasting Protocol
Understanding fasting and cell regeneration helps you make a fasting plan that works best for you. This plan can help you live longer and look younger.
Creating a fasting plan means thinking about how long and how often you fast. It also depends on your health goals. For example, some people might choose a 72-hour fast. Others might prefer the 16:8 or 5:2 methods.
It’s important to listen to your body when fasting. You might need to change your fasting plan based on how you feel. This could mean trying different fasting times to see what works best for you.
In the end, a good fasting plan can greatly improve your health. It can help you live longer and look younger too.
FAQ
What is autophagy and how does it relate to cell regeneration during fasting?
Autophagy is a natural process where cells clean out damaged parts. This helps keep cells healthy and balanced. When you fast, autophagy kicks in, helping your cells renew and stay healthy.
How long do I need to fast to activate autophagy?
Autophagy starts within 12-16 hours of fasting. It gets even stronger between 24-48 hours. Fasting for more than 72 hours can make autophagy last longer.
What are the benefits of a 72-hour fast for cell regeneration?
A 72-hour fast is the best for cell renewal. It boosts stem cell production and resets your immune system. It also extends autophagy, improving overall health.
Are there any risks or contraindications associated with prolonged fasting?
Yes, fasting for a long time isn’t safe for everyone. It’s not good for those with eating disorders, certain health issues, or taking some medicines. Always talk to a doctor before fasting for a long time.
How do I safely break a prolonged fast?
Breaking a long fast safely means starting with small amounts of healthy food. Watch how your body reacts. This helps keep the fasting benefits and avoids bad side effects.
Can intermittent fasting methods, such as 16:8 or 5:2, be effective for cell regeneration?
Yes, methods like 16:8 and 5:2 can help with cell health. They might not be as strong as long fasting. But they can also start autophagy and help cells renew.
How often should I fast to maintain optimal cell regeneration?
How often to fast depends on your health and goals. Some like regular short fasts, while others prefer longer ones. Always check with a doctor to find what works best for you.
Can fasting help with anti-aging and longevity?
Yes, fasting can help you age better. It boosts cell renewal, improves metabolism, and lowers stress. Regular fasting can keep you healthy and help you age well.
Are there any specific nutrients or supplements that can enhance the effects of fasting on cell regeneration?
Some nutrients and supplements, like antioxidants and omega-3s, can support health during fasting. But, always talk to a doctor before adding anything to your fasting routine.
References
- Cheng, C. W., Adams, G. B., Perin, L., Wei, M., Zhou, X., Lam, B. S., … & Longo, V. D. (2014). Prolonged fasting reduces IGF-1/PKA to promote hematopoietic-stem-cell-based regeneration and reverse immunosuppression. Cell Stem Cell, 14(6), 810-823. https://doi.org/10.1016/j.stem.2014.04.014
- Madeo, F., Zimmermann, A., Maiuri, M. C., & Kroemer, G. (2015). Essential role for autophagy in life span extension. The Journal of Clinical Investigation, 125(1), 85-93. https://doi.org/10.1172/JCI73946
- Raffaghello, L., Lee, C., Safdie, F. M., Wei, M., Madia, F., Bianchi, G., & Longo, V. D. (2008). Starvation-dependent differential stress resistance protects normal but not cancer cells against high-dose chemotherapy. Proceedings of the National Academy of Sciences, 105(24), 8215-8220. https://doi.org/10.1073/pnas.0708100105
- Brandhorst, S., Choi, I. Y., Wei, M., & Longo, V. D. (2017). Fasting and Caloric Restriction in Cancer Prevention and Treatment. Annual Review of Medicine, 68, 41-56. https://doi.org/10.1146/annurev-med-061315-014634
- Wilkinson, M. J., Manoogian, E. N. C., Zadourian, A., Lo, H., Fakhouri, S., Shoghi, A., … & Panda, S. (2020). Ten-hour time-restricted eating reduces weight, blood pressure, and atherogenic lipids in patients with metabolic syndrome. Cell Metabolism, 31(1), 92-104.e5. https://doi.org/10.1016/j.cmet.2019.11.004